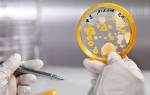

Механизм действия ботокса
Действующим веществом препарата, который вводят подкожно для омоложения, является ботулотоксин. Он вызывает блокаду передачи импульсов в мышцах, за счет чего мимические мышцы расслабляются, он имеет токсическое действие. По этой причине не стоит проводить эксперименты и пить алкоголь после ботокса, так как последствия могут быть непредсказуемые. Часто последствиями алкоголизма является противопоказанием к проведению косметической процедуры. Вещество для омоложения вводят подкожно, потому важно для нормального усвоения стабильное состояние крови.
Вводя препарат под кожу, становится возможным справиться с разными неврологическими и косметическими проблемами лица шеи. Происходит разглаживание мышц, эффект которого держится до определенного периода. По мере выведения препарата с организма, мышцы возвращаются в то положение, в каком были до процедуры. В зависимости от качества препарата и от дозировки, необходимость повторного курса уколов возникает через 3-12 месяцев.
Это интересно! После ботокса не теряется чувствительность кожного покрова, если правильно сделаны уколы, то токсин не мигрирует в другие области. Препарат в косметологии используют на протяжении 20 лет, что говорит о качестве и безопасности процедуры для состояния здоровья.
Влияние алкоголя на активность ботокса
Доказано, что спиртное оказывает лишь опосредованное влияние на результат омоложения ботоксом. Однако даже косвенное воздействие приводит к негативным последствиям, которых можно избежать.
- Во первых, любые спиртосодержащие напитки способствуют расширению кровеносных сосудов и усиливают кровообращение в мышцах, куда были сделаны уколы. Активное движение жидкостей в межклеточном пространстве грозит выходом токсина за пределы инъецированного волокна и распределением в соседних тканях. В результате — парализуются нецелевые мышцы, что чревато не только нежелательными косметическими дефектами, но и нарушением функциональности отдельных участков.
- Во-вторых, спиртное способно ослаблять действие ботулотоксина, поскольку ускоряет его выведение. Это также происходит из-за расширения кровеносных сосудов, которое случается, если выпить коньяк или вино. По этой же причине на пару дней стоит отказаться от кофе. Кофеин заставляет сосуды пульсировать, то сжимаясь, то расширяясь. Если это не учитывать, можно получить невыраженный и неудовлетворительный результат или его отсутствие. Возможно, что достигнутый эффект сохранится на несколько месяцев меньше.
Противопоказания к проведению процедуре
Инъекции подкожно не является операцией, но оказывает значительное влияние на жизнедеятельность организма, так как являются медицинским препаратом. Ботокс противопоказано при:
- онкологии, заболевании почек, дыхательных путей;
- в период месячных;
- глазных болезнях;
- аллергии на компоненты;
- нельзя пить алкоголь;
- до и после процедуры физические нагрузки;
- прием антибиотиков;
- массаж частей тела, где произведена инъекция.
Алкоголь и аналоги ботокса
Любой препарат, содержащий ботулотоксин, нельзя совмещать со спиртным. Ведь принципиальных отличий в составах нет, везде одно действующее вещество и различные дополнительные компоненты.
Существует теория, что более выраженное влияние оказывается на ксеомин, чем на средства, в основе которых нейротоксин и вспомогательные белки. Поскольку ксеомин имеет невысокую молекулярную массу, он подвижен и обладает способностью растекаться. Под воздействием алкоголя его диффузия может значительно усиливаться.
Буянов Сергей Юрьевич (Врач-эксперт):
Теоретически ботулотоксин, связанный с белками, наиболее защищён от взаимодействия с алкоголем, так как движется целенаправленно к нервным синапсам, и только после этого высвобождается из «оболочки». Никаких исследований в этой области не велось и навряд ли ожидается в будущем, поэтому не рекомендуется рисковать и проверять действие алкоголя после инъекции ботулотоксина до двух недель.
Фото до и после
Можно ли пить алкоголь после процедуры
Спиртное и ботокс не совместимы. Спиртосодержащие напитки расширяют сосуды, усиливают кровоток, что может привести к самым плачевным результатам. Самое минимальное при совместимости с ботоксом алкоголь может сделать, так как это уменьшить действие препарата, вплоть до его распада. При попадании спирта в кровь, эритроциты склеиваются, тормозится доступ тканей к кислороду, а сами стенки сосудов становятся рыхлыми менее эластичными, возникают сосудистые звездочки и другие неприятные проблемы.
Алкоголь оказывает особенное влияние на ботокс. Введенный препарат может сдвинуться либо распространится на другую область и может сохраняться в новом месте длительное время. И даже если в день клиентка выпила немного коньяка после ботокса, может повлечь немалые суммы денежных средств на восстановления нормальной внешности. Спиртосодержащие напитки после ботокса, в том числе вино может повлечь осложнения:
- покраснения отеки;
- блокада круговых мышц губ;
- искажение формы лица;
- асимметричность контура;
- каменное выражение лица.
Асимметричность, паралич мышц лица вызывает проблемы с жеванием пищи. Потому важно выбирать красота и молодость либо алкоголь.
Если запланировано мероприятие, на котором невозможно отказаться, необходимо заранее перенести процедуру инъекции. Лучше придерживаться строго рекомендаций врачей, чем потом откладывать все дела и решать последствия.
Естественно для многих стоит вопрос можно ли пить безалкогольное пиво при процедуре ботокса. Все напитки крепостью меньше 3% разрешены только в небольших дозах. Но лекарственные препараты (настойки, экстракты) содержать спирт, потому необходимо отложить их потребление. Но если терапию лекарственными препаратами невозможно остановить либо заменить другими средствами, то лучше использовать другие методы для улучшения внешнего вида.
Ботулотоксин затормаживает расщепление спирта в организме и концентрация ацетальдегида в 10 раз. Происходит токсикация организма, которая выражается в приступе тошноты, приступах паники, нарушении пищеварения, одышку. Некоторые специалисты по силе действия на организм, сравнивают алкогольное отравление с ботулизмом. При психических нарушениях сочетание ботокса и алкоголя вызывает помутнение сознания, разного рода галлюцинации. В тех, кто страдает гипертонией, наблюдается скачки давления.
Интересно! После ботоксотерапии не стоит использовать косметические средства на основе спирта, так как продукт может впитываться через кожу и расширять кровеносные сосуды.
Что происходит, если употреблять алкоголь после инъекций
Ботокс, как и любой спиртной напиток, является токсическим ядом. А потому сочетание их в организме может привести к печальным последствиям. Алкоголь стимулирует работу ЦНС и сердца. Ботулотоксин тоже оказывает воздействие на ЦНС. За сколько дней нужно прекратить принимать спиртное? Врачи рекомендуют не пить хотя бы день непосредственно перед инъекцией. Иначе есть вероятность появления гематом на месте укола. Также существуют такие уколы вокруг глаз.
Реакции, происходящие в организме при приеме спиртных напитков и ботулотоксина:
- Спирт в организме окисляется и начинает распадаться на мелкие вещества.
- Идет “сбой” в ЦНС. Человек может даже начать видеть галлюцинации.
- Полная интоксикация, ведущая к сильному отравлению.
Можно ли алкоголь совместить с инъекцией? Существует миф, что спиртное перед уколами якобы уменьшает болезненные ощущения. Специалисты утверждают, что это не так. Спирт производит возбуждающий эффект на организм человека. Он не блокирует болезненные ощущения, а, наоборот, обостряет их. А про ботокс в подмышки можно узнать по ссылке.
Следует понимать, что даже врачи не могут предсказать, насколько сильно повлияет “гремучая смесь” на пациента в каждом индивидуальном случает. Вот почему нельзя пить алкоголь перед уколами. Многий пациент уверен, что если выпить небольшое количество спиртного, то последствия никак не проявятся, и зачастую ошибается.
Через какое время можно употреблять спиртное?
Не известно, как алкоголь влияет как ботокс, но лучше определенное время отказаться от выпивки. Нельзя пить после ботокса столько, сколько рекомендуют косметологи. Минимальное количество времени воздержания 2-3 недели. Затем количество допустимой дозы врачами выпитых спиртосодержащих напитков сокращают в 3 раза до окончательного выведения с организма препарата ботулотоксина.
В индивидуальном порядке, когда можно пить алкоголь после ботокса, косметолог скажет более точно. Не стоит самостоятельно решать можно совмещать алкоголь и ботокс, так как это может отразиться на внешности и здоровье. Даже для снятия дискомфорта не стоит пренебрегать советами врача.
Важно! Даже минимальное количество может принести вред.
Об ответственности врача
Ни один консультант не даст вам стопроцентно точного ответа на вопрос: через сколько можно пить после ботокса. Это всегда выглядит как рекомендация. При этом квалифицированный и опытный специалист прекрасно знает о возможных последствиях. Его задача: предупредить и не навредить. Поэтому мы четко описываем проблемы, с которыми может столкнуться тот, кто не руководствовался советами врача и своего косметолога. Даже специалист, который сделал не одну тысячу уколов с чудодейственным омолаживающим ботулотоксином, не сможет предсказать или угадать, какая реакция будет именно у вашего организма, если в гипотетической ситуации, можно ли спиртное после уколов ботокса, вы ответите себе «можно!». Слишком велика ответственность и риски. При этом запретить вам тоже никто не сможет.
Что делать если выпила после процедуры ботокса?
Распространение мифы о не совместимости алкоголя и ботокса, якобы спиртные напитки нейтрализуют действие препарата полностью. На самом деле если молекулы ботокса приникают в мышцы, то обязательно подействует. Только при индивидуальных особенностях организма или при не правильном введении, препарат может не действовать. Если после процедуры ботокса употребляли алкоголь, то эффект может ослабиться.
Чтобы уменьшить влияние алкоголя, не стоит пить крепкий чай либо кофе, использовать народные методы для очищения кишечника. Также стоит избегать применения лекарственных препаратов для выведения спиртовых соединений. Необходимо прогуляться на свежем воздухе, и пить больше чистой воды.
Допускается ли алкоголь перед процедурой
Клиентки косметологических центров обычно заранее выясняют, как правильно подготовиться к процедуре. Один из наиболее распространённых вопросов касается того, можно ли употреблять спиртное.
Специалисты убеждены, что лучше этого не делать непосредственно перед уколами. Хорошо, если пациентка будет вести трезвый образ жизни как минимум 3-4 дня до вмешательства. Такой срок необходим для полного выведения этанола из тканей тела.
Обычно его распад завершается выделением уксусной кислоты на вторые сутки после застолья, однако этому предшествует этап окисления этилового спирта до ацетальдегида, обладающего высокой степенью токсичности. Ещё одна особенность этого вещества – накапливание в мягких тканях. Важно, чтобы на момент введения ботокса данного соединения не было.
Пить спиртное перед посещением салона не стоит. Если внутри тела будут одновременно присутствовать и этанол, и ботокс, то последствия непредсказуемы. Есть вероятность, что процедура не даст предполагаемого результата. Это означает, что женщина будет терпеть дискомфорт, а морщины так и останутся на её лице. Воздержание от всех видов спиртных напитков – одна из составляющих успешности косметологической процедуры омоложения.
Важно! Ограничение в приеме спиртного не единственное на подготовительном этапе. Женщине запрещают активные физические нагрузки и приём некоторых лекарственных средств, в частности антибиотиков. Если запланированная манипуляция выпадает на менструальную фазу цикла, то лучше всего перенести её на более благоприятный период.
Негативные последствия после употребления спиртного
Алкогольные напитки негативно действуют на состояние кожи. У женщин последствия злоупотребления становятся более заметней, чем у мужчин. Это проявляется в:
- потери эластичности и упругости;
- появлении морщин вокруг глаз, носогубные морщины становятся более четкими;
- цвет лица становится тусклым, приобретает серый оттенок;
- увеличиваются поры, кожный покров становится сухим и происходит шелушение.
Учитывая эти факторы, становится очевидно, что молодость и употребление спиртосодержащих напитков недопустимо. При не соблюдении рекомендаций врача может наблюдаться неожиданный эффект:
- опущение верхнего века, иногда до полного его закрытия;
- поднятие бровей;
- упущение уголков рта;
- невозможность выразить любую эмоции.
Можно ли принимать алкоголь, если ботокс вводят в лоб? Специалисты отмечают, что наблюдается опущение одной брови либо обеих, с соответственным выражением лица плачущего человека. Кроме того, усиливаются побочные действия (оттеки, гематомы, шишки). Также пациентки жалуются на:
- головокружение;
- общий отек лица, тошноту;
- сухость во рту;
- болезненные ощущения в местах укола.
В состоянии опьянения можно проигнорировать любые другие противопоказания, к примеру, посещение бани, сауны и прочее.
В некоторых случаях сочетание провоцировало сгущение крови и образование тромбов. Возникает риск острой эмболии, что чревато летальным исходом.
Совет! После инъекций ботокса важно нельзя употреблять алкоголь, ровно столько, сколько укажет врач. Изменения во внешности – весомый аргумент, почему нельзя пить алкоголь при ботоксе.
Уколы ботокса и алкоголь: влияние на нашу кожу
Неприятный эффект от алкоголя проявляется и на коже, она не всегда быстро демонстрирует это. Кстати, чаще всего у женщин побочные эффекты начинают появляться гораздо быстрее, чем у мужчин. Обезвоженная кожа сохнет, теряет эластичность и истончается. Алкоголь вымывает большинство питательных веществ и минералов из нашего организма, что мгновенно сказывается на качестве и состоянии эпидермиса. Появляются синяки под глазами или становятся заметнее, верхнее веко неприятно нависает, вокруг глаз становится больше морщин, носогубные складки увеличиваются и становятся глубокими и ярко выраженными. Кожа бледнеет и приобретает землистый оттенок. Сколько нельзя пить после уколов ботокса, когда можно пить после уколов ботокса – разве эти вопросы должны серьёзно волновать того, кто в принципе задумывается о своем здоровье?
Выше мы перечислили негативные последствия употребления. Но самое любопытное, что все перечисленные проблемы могут являться показаниями для инъекций ботокса, поскольку он-то как раз и поможет наполнить нашу кожу силой и жизненной энергией. Но без помощи организма и вашего терпения ему не справиться.
Уколы с ботулотоксином под кожу – это очевидная поддержка для естественных регенерирующих процессов, которая всё же является искусственным вмешательством для организма. А значит, это стресс и увеличение нагрузки для него, пусть и не явные. Поэтому ответ на вопрос, почему после уколов ботокса нельзя пить алкоголь, очевиден: это тоже стресс для организма.
Запишитесь на прием в клинику на Васильевском острове
Записаться
Алкоголь перед ботоксом
Прежде чем приступить к процедуре, поговорите со специалистом. Квалифицированная консультация в нашей клинике откроет вам глаза на внутренние процессы и расскажет о тонкостях ботулинотерапии. Зная нюансы, вы сможете иначе взглянуть на механизм процедуры и вникните в процессы, которые запускает ботокс под кожей. Кроме того осознаете, что помимо общего вреда, спиртные напитки, употребляемые даже до процедуры, могут повлиять на качество результата после инъекций.
Нашим пациентам, спрашивающим «можно ли пить перед ботоксом», мы отвечаем просто: всё же рекомендуем как минимум сутки воздержаться от возлияний. Особенно это касается напитков с высоким содержанием в них спирта. Любой врач объяснит вам, что алкоголь выводится из организма не один день. Конечно, всё зависит от массы тела и индивидуальных особенностей, но для среднестатистического человека совет однозначен: 24 часа до сеанса без алкоголя. А ещё лучше – три дня. Достаточно просто потерпеть и выдержать, если вы хотите максимального эффекта от инъекций.
Если всё-таки вы не последовали рекомендациям, то будьте готовы к появлению синяков в области уколов. Дело в том что алкоголь разжижает кровь, истончает стенки сосудов, замедляет регенерацию кожи и может ухудшить состояние кожи в местах инъекций. Гематомы на лице после ботулинотерапии несут не самый радужный эффект. А ставшие крупными поры, шелушение кожи – это тоже последствия употребления алкоголя ещё до проведения процедуры.
Рекомендации косметологов
Профессиональный косметолог после процедуры ботокса объяснит, почему нельзя пить спиртное. За 3 дня организм выводит алкоголь с крови, потому перед уколами необходимо не употреблять в течение этих дней. А в течение 10 дней организм перестраивается, потому важно воздерживаться после процедуры то время, которое укажет врач в индивидуальном порядке. Если рекомендации игнорировать, то негативный результат будет, зависит от крепости напитка и его количества.
После инъекции ботокс рекомендуют избегать тепловых нагрузок (сауны и бани), чтобы результат имеет желаемой эффект, и по этой причине, почему нельзя употреблять алкоголь, необходимо отказаться от спиртного. Хотя явных противопоказаний нет, почему нельзя алкоголь при ботоксе, но лучше на время отказаться. После ботокса выпивать алкоголь можно лишь через 2 недели.
Рекомендация косметологов сводится к одному, не стоит ставить опыты над своим телом и внешностью.
А какие существуют мифы о ботоксе, которые все принимают за чистую монету?
Можно ли употреблять алкоголь до процедуры
Косметологи рекомендуют отказаться от употребления алкоголя за неделю перед проведением инъекций. Это касается всех спиртных напитков, в том числе белого вина, безалкогольного пива. Спирт считается одним из сильнейших токсинов, оказывающим влияние на все системы и органы. Не стоит путать выход из состояния опьянения и вывод спирта из организма. У женщин скорость нейтрализации меньше на 20% чем у мужчин. Чем выше градус и больше объем выпитого, тем сложнее ферментам восстановить нормальное состояние. Для выведения пива потребуется несколько часов, для коктейлей, содержащих водку или коньяк, — около суток.
Перед проведением инъекций ботокса нельзя принимать алкогольные напитки в течение 7 дней. Можно употреблять за месяц, это не повлияет на результат при условии, что выпитое не спровоцирует обострение хронических состояний. Наибольшие риски связаны с употреблением за сутки, предугадать эффект инъекций не смогут даже профессионалы с большим опытом работы.
Спиртное приводит к резкому расширению, а затем сужению сосудов, что может помешать паралитическому действию. Это самый благоприятный сценарий, другие побочные явления могут привести к лицевой асимметрии, образованию бугорков. Для выведения препарата придется приложить много усилий, потребуется курс массажей, аппаратных процедур. Возможен запуск процессов старения, и вместо молодого красивого лица придется бороться уже с более глубокими, заметными морщинами. Поэтому, чтобы избежать рисков непредвиденных реакций, лучше отказаться от любых спиртных напитков даже в минимальном количестве.
Обзор реальных отзывов пациентов
Некоторые отмечают, что выпитое спиртное после ботокса, уменьшает продолжительность эффекта уколов, буквально укорачивает в 2 раза. Придерживаясь рекомендованного периода, улучшает протекание реабилитационного периода. Дальнейший период времени действия ботокса, сколько не пить алкоголь решает сама клиентка. Некоторые отказываются вовсе, другие отмечают, что выпив, не наблюдают никаких последствий даже в день инъекции.
Некоторые отзывы содержать сообщение о том, что совмещая ботокс и алкоголь, не было никаких побочных действий. Но не стоит опираться для себя на такие отзывы, так как каждый человек индивидуален, соответственно и реакция организм может быть разной.
Можно ли пить алкоголь после ботокса решать каждой женщине, но важно помнить, что приходя в кабинет косметолога для решения одной проблемы, после выпитого существует риск получить много других.
При запрете на алкоголь после процедуры, стоит точно усвоить ответ на вопрос, можно ли пить алкоголь перед ботоксом. Важно воздерживаться от спиртосодержащих продуктов, так как они оказывают негативное действие.
Показания и противопоказания к применению уколов
Инъекция ботокса для лица представляет собой процедуру по омоложению кожи. Препарат предназначен для разглаживания морщин, а потому часто колется в лоб. Сразу же после укола мышцы начинают расслабляться, а морщины – разглаживаться. Инъекции рекомендуют делать при первых признаках образования морщин и складочек вокруг носа, глаз, губ, на лбу и шее. А можно ли делать ботокс для волос беременным узнаете тут.
Суть уколов ботулотоксином состоит в том, что бактерии, входящие в состав вещества, устремляются к мышцам и вызывают полный паралич. За счет их расслабления исчезают мимические морщины. Эффект длится от 6 до 9 месяцев, после чего ботокс выходит из организма, не принося ему вреда, аналоги ботокса выводятся быстрее.
Поскольку укол ботокса представляет собой химическую процедуру, то есть ряд противопоказаний. Среди них:
- беременность и кормление грудью;
- возраст пациента не меньше 18, но и не больше 65 лет;
- аллергия на препарат;
- ОРВИ, туберкулез и другие инфекционные заболевания;
- патологии крови;
- болезни почек, печени, ЖКТ;
- период менструации;
- онкология;
- ВИЧ;
- недавняя хирургическая операция.
Кроме того, перед уколами нельзя пить алкоголь! Спиртные напитки могут привести к отравлению и другим неприятным последствиям. А про ботокс для волос можно узнать здесь.
На видео- ботокс и алкоголь:
Употребление безалкогольных спиртных напитков
Безалкогольное вино или пиво, чаще всего, содержит небольшой процент этанола – от 0,5 до 1,5 градусов. Современные технологии, использующиеся при производстве, не позволяют полностью выветрить спирт из напитка. В одном бокале содержится совсем немного спирта, такое количество не окажет никакого вреда. Но если хрупкая женщина, весом 50-60 кг выпьет более литра, она почувствует опьянение. Поэтому «нулевые» напитки можно пить, но совсем немного – несколько глотков вина или маленькую кружку пива.
Когда можно будет пить спиртное после ботокса
Это самый частый вопрос, который задают пациенты своему косметологу. Однозначного ответа на него нет, поскольку алкоголь влияет на каждого человека по-своему.
Большинство врачей сходятся во мнении, что принимать алкогольные напитки после процедуры можно только через неделю или лучше две.
За этот период времени полностью сойдут все уплотнения, синяки на коже, лекарство равномерно распределиться по мышечному волокну, окажет свое действие на нервные окончания.
Имеется зависимость между крепостью спиртного и нежелательными эффектами. Крепкий алкоголь (водка, коньяк) оказывает свое действие сильнее, чем слабый (вино, шампанское, пиво).
Кроме спиртного врачи не рекомендуют употреблять некоторые безалкогольные кофеиносодержащие напитки: горячий кофе, чай. Они могут вызвать отечность тканей лица, ухудшить состояния мест инъекций, удлинить период их заживления.
Действия после применения инъекций «Ботокса»
Сколько после ботокса нельзя пить алкоголь? От него стоит отказать на 4–7 дней, это минимум, а также от курения. Рассмотрим другие рекомендации:
- Не ложиться около четырех часов.
- Три дня не прикасаться к месту, где вводился препарат, не массировать.
- Необходимо отказаться от перелетов на сутки.
- Не наклоняться вниз, стоит ограничить физическую нагрузку.
- Две недели нельзя посещать сауны, бани и солярий.
- Два-три дня соблюдать диету, а именно не кушать соленые и острые продукты, употреблять немного жидкости.
- Две недели не принимать антибиотики и аспирин.
На вопрос о том, сколько дней после ботокса нельзя пить алкоголь, мы ответили коротко, ниже поговорим более подробно. Стоит также отказаться на две недели от спиртосодержащих препаратов.
Возможные последствия
Употребление алкоголя после инъекции ботокса может стать причиной разнообразных осложнений:
- слабовыраженный результат процедуры или его отсутствие;
- появление заметных бугров, отеков, гематом в области инъекции;
- признаки интоксикации – тошнота, рвота, головокружение;
- медленное заживление;
- сильное покраснение в зоне укола;
- эффект восковой маски, когда мышцы обездвижены настолько, что мимики практически нет.
Но нельзя употреблять алкоголь после ботокса не только из-за несоответствия результата ожиданиям. В некоторых случаях последствия могут быть крайне серьезными – у пациента может начаться легочный паралич, который при отсутствии своевременно оказанной медицинской помощи может стать причиной смерти.
Полезные рекомендации
Для достижения положительного эффекта от укола красоты нужно не только выбрать грамотного специалиста, но и самой соблюдать некоторые ограничения, правила до и после инъекции.
Предлагаем ознакомиться: Как действует кодировка от алкоголя уколом
Перед проведением косметической процедуры рекомендуется выполнить несколько простых советов:
- Не стоит пить успокоительные препараты, антикоагулянты и прочие лекарства, влияющие на центральную нервную системы и кровообращение. Разного рода антибиотики могут ухудшать свертываемость крови.
- Нужно помнить, что нельзя сильно наклонять голову. Иначе кровообращение в области лица усилится, и препарат может распределиться неправильно.
- Не стоит делать массаж участка тела, в который планируется ввести укол красоты.
- Не рекомендуется спать лицом вниз.
- Необходимо сохранять спокойствие, избегать стрессовых ситуаций и меньше волноваться.
- Категорически запрещено употреблять спиртные напитки любой крепости. Это чревато появлением гематом и синяков.
- В день процедуры необходимо свести к минимуму физические нагрузки (особенно те, что предполагают наклон головы), а от спортивных тренировок рекомендуется совсем отказаться.
После введения инъекции ботулотоксина не рекомендуется:
- Трогать и растирать кожу руками хотя бы на протяжении 2 дней, поэтому запрещается любой массаж.
- Необходимо сохранять лицо чистым, а значит, стоит воздержаться от нанесения разного рода косметических средств.
- На протяжении 10 дней после процедуры рекомендуется избегать таких мест, как баня, сауна, бассейн.
- Нельзя загорать.
- Необходимо минимально использовать мимику лица.
- В первое время следует уменьшить количество тренировок и других физических нагрузок.
- Запрещено употреблять алкоголь.
- Горизонтальное положение можно принимать не раньше чем через 5 часов.
Эффект от инъекции будет заметен через 3-5 дней: мышцы расслабятся, а морщинки разгладятся.
Необходимо тщательно следить за своим здоровьем: высокая температура, зуд, жжение — это повод для немедленного обращения к косметологу.
Инъекция ботокса — это непростая процедура, которая может нанести вред здоровью человека, если не соблюдать рекомендации косметолога и безответственно подходить к периоду реабилитации. Проводить манипуляцию рекомендуется только в зрелом возрасте при объективной необходимости по рекомендациям специалиста.
Прежде чем сделать укол ботокса, стоит обратить особое внимание на такие рекомендации:
- Нельзя сильно волноваться и нервничать.
- Лицом вниз лежать нельзя.
- Не стоит массажировать ту часть лица, куда будет делаться инъекция.
- Не стоит сильно наклонять голову.
- Не следует принимать антикоагулянты, успокоительные и прочие лекарственные препараты, которые могут оказывать влияние на кровеносную и центральную нервную систему.
Нельзя после проведения манипуляций:
- Принимать горячительные напитки.
- На протяжении первых нескольких дней лучше не выполнять наклоны и занятия спортом.
- Сильно задействовать мимику нежелательно.
- Не стоит загорать.
- В течение 10 суток не рекомендовано посещать бассейн, сауну или баню.
- Наносить на лицо косметические средства.
- После проведения манипуляции запрещено на протяжении 5 часов ложиться спать.
- Растирать и трогать руками кожный покров. Лучше не прикасаться к нему вообще на протяжении 2 суток.
В этом состоянии человек должен хорошо следить за состоянием своего здоровья. Если появятся отёк, жжение, зуд, повышенная температура, то сразу необходимо обратиться к косметологу. Конечный результат от поставленной инъекции будет заметен через 3—5 суток. При этом мышцы начнут расслабляться, а морщины — разгладятся.
Длительность эффекта зависит от особенностей организма, но в целом составляет 6—8 месяцев. Его можно продлить, если у человека не будет вредных привычек, он будет вести здоровый образ жизни, хорошо питаться и высыпаться.
Процедура омоложения ботоксом является очень сложной. Она может нанести серьёзный вред здоровью. Чтобы этого не допустить, необходимо соблюдать все рекомендации специалиста и хорошо подумать, стоит ли омолаживаться именно таким способом, ведь существует множество других и более безопасных.
А ещё необходимо найти хорошего косметолога. Именно от него зависит результат и ваше здоровье. Если вы получили определённый дискомфорт после первой консультации, то не нужно стесняться отказаться от услуг этого доктора, а стоит найти более квалифицированного. Обговорите подробно то, какой именно результат вы желаете получить. Ведь можно измениться до неузнаваемости, если убрать лишь одну морщину.
Что это за процедура?
Это введение под кожу специальными иглами в мимические мышцы нейротоксина типа «А» белковой природы в микроскопической дозе. Вследствие этого мышцы расслабляются, но не атрофируются, потому что вещество не попадает в кровообращение, кожа приобретает подтянутый вид, а злосчастные бороздки исчезают.